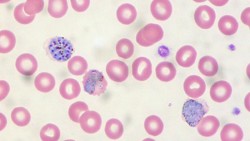

Kenya Alliance Against Malaria
Movilizando recursos para lograr el acceso equitativo a la atención primaria.
La Alianza Contra la Malaria de Kenia une a las organizaciones no gubernamentales que trabajan para prevenir, controlar y reducir la tasa de mortalidad causada por la malaria. La alianza cree que el esfuerzo de las organizaciones tiene que ser conjunto para ofrecer mejores resultados y más efectivos. Kenamm está también introduciendo en sus programas otros problemas de salud para tener una visión más global y de este modo poder mejorar y contribuir a mejorar la salud de las franjas más vulnerable de la población.
- Tags: Atención sanitaria, África, I+D+I, Industria farmacéutica, Malaria, Medicamentos, Pobreza, Salud pública
- Web: kenaam.org
- En las redes:
- Contacto
Wilson Airport, Langata Road, P.O.Box 30125
00100 Nairobi, 254 Kenya
Teléfono: +254 (0)20 6994904/ 4432
Email: info@kenaam.org
Malaria: Killer Number One
La magnitud del poder de destrucción de una enfermedad depende directamente de las condiciones del entorno.




